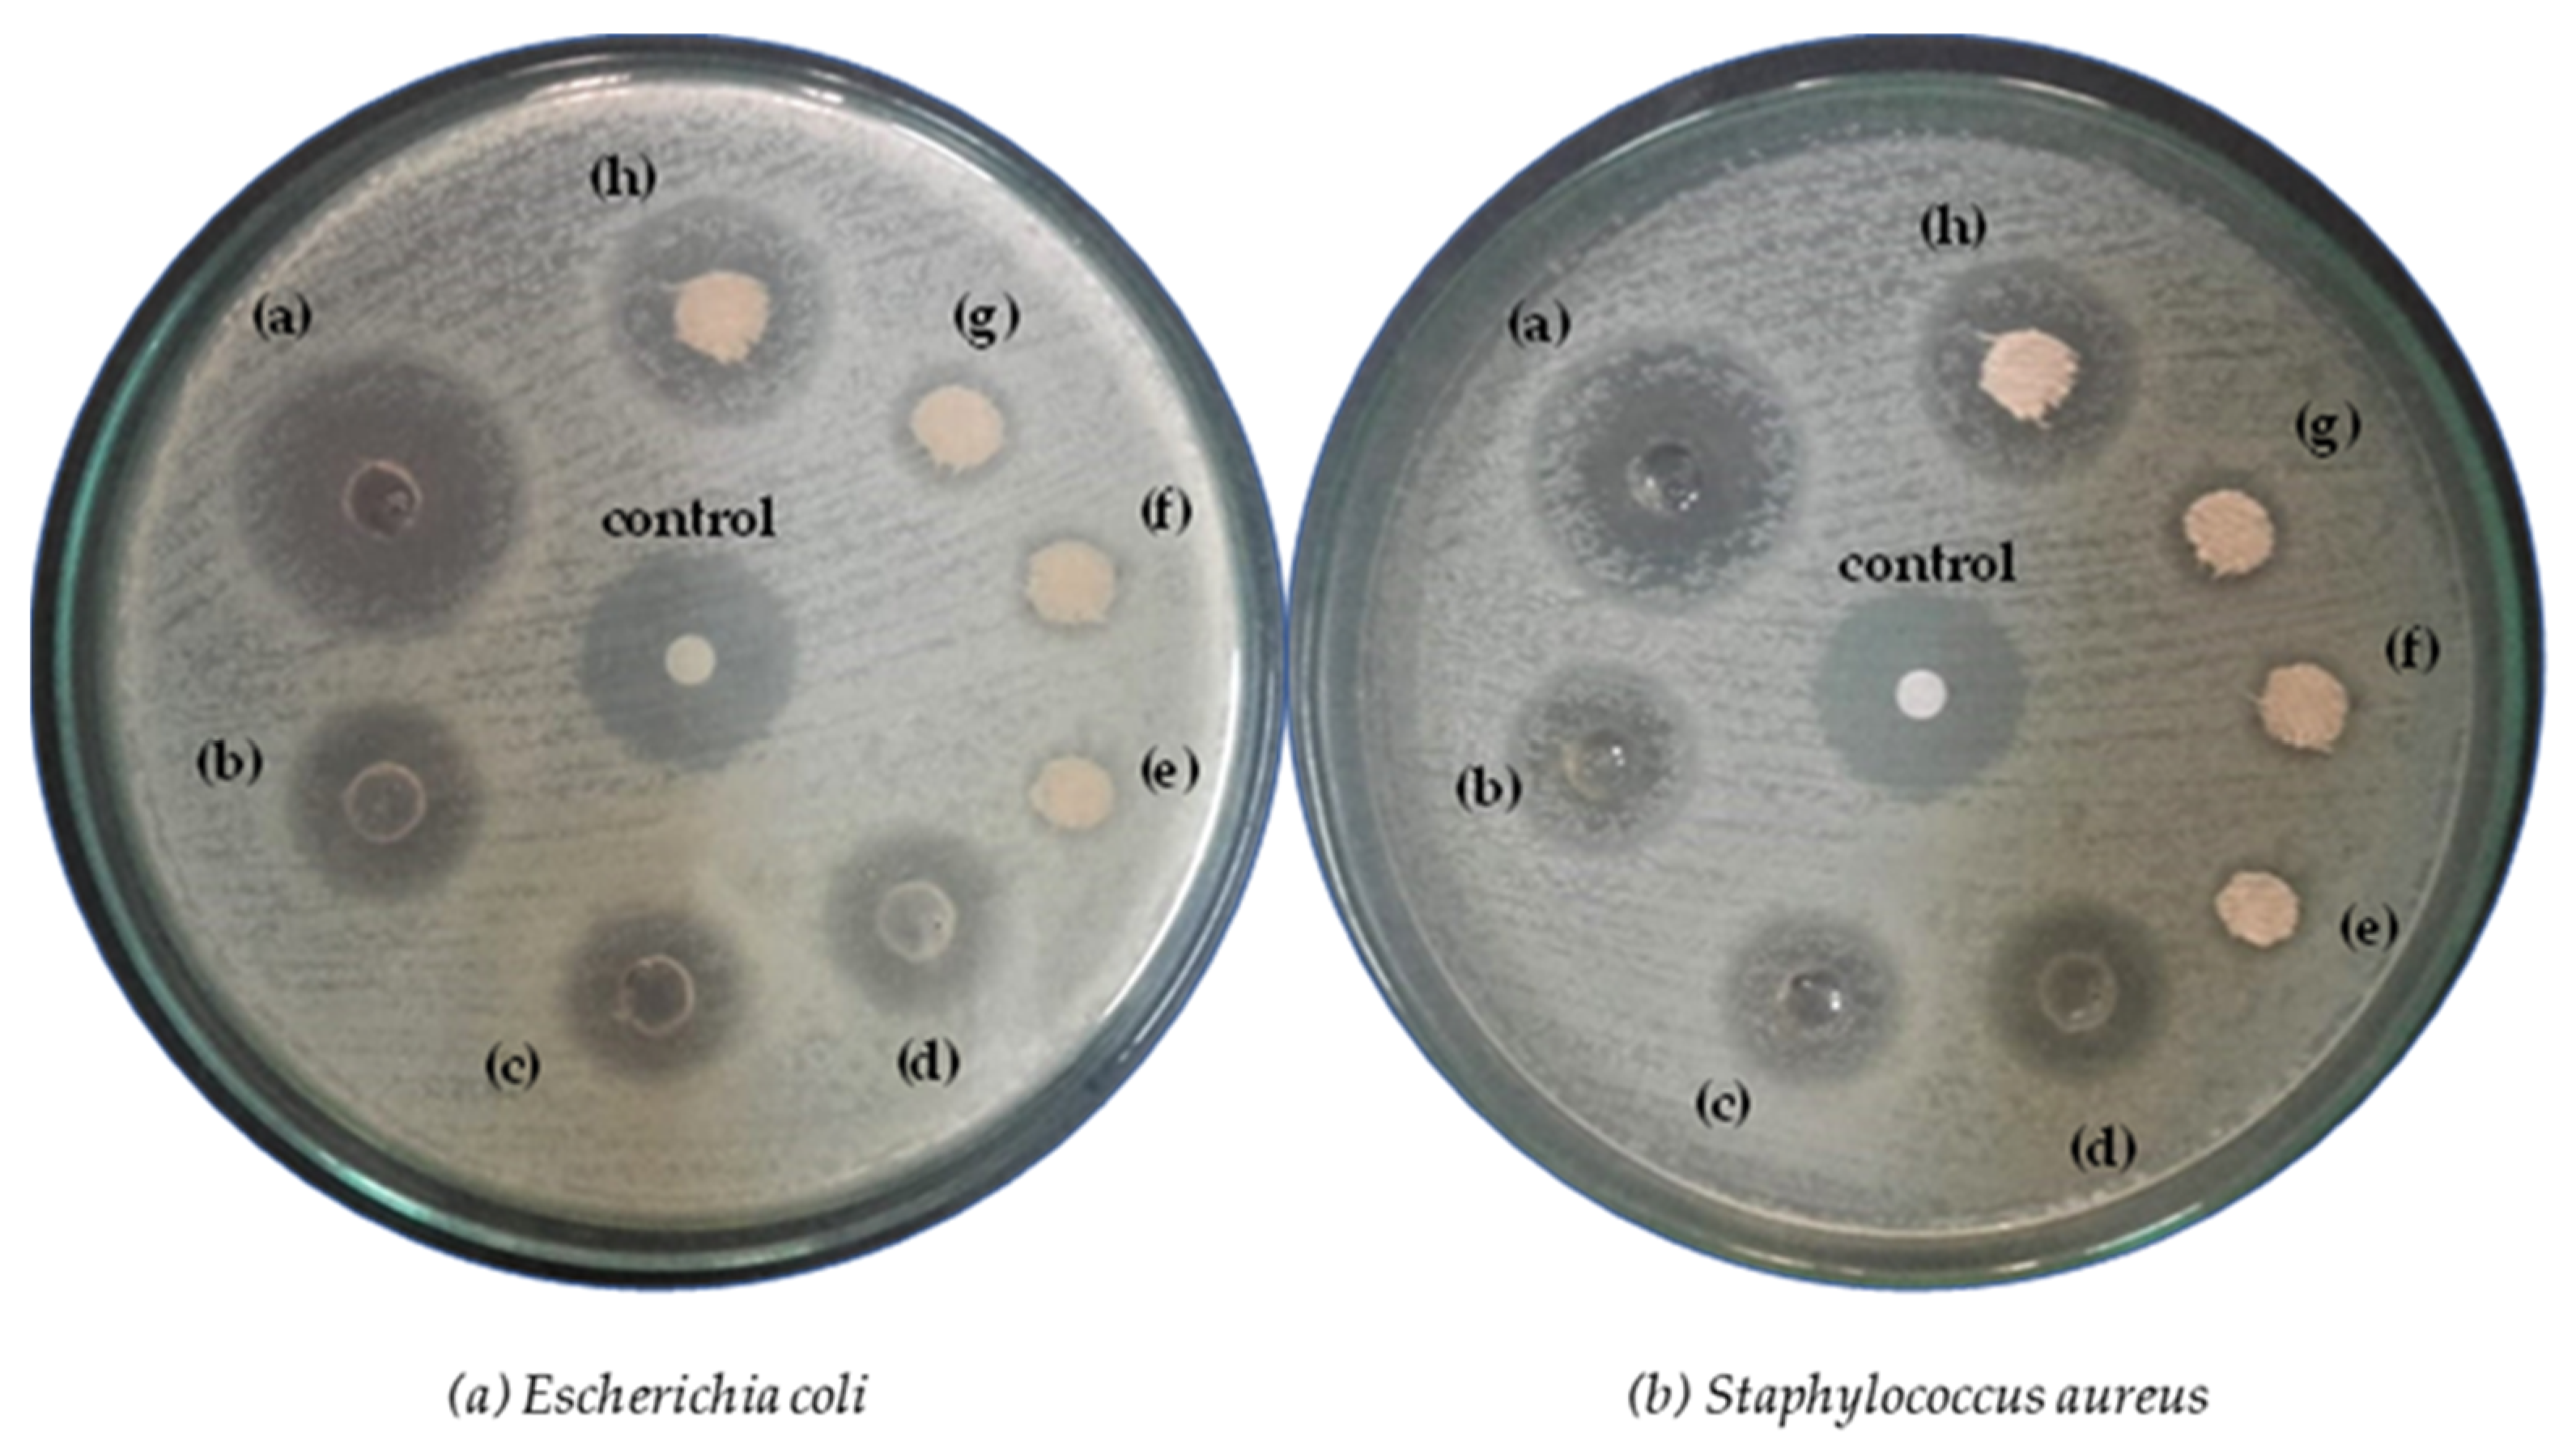
Coatings 13 00623 g003 Coatings 13 00623 g003

Extraction of Anthocyanin from Rose Petals for Coloration of Biomordanted Wool Fabric
Abstract
1. Introduction
2. Materials and Methods
2.1. Collection and Preparation of Samples
2.2. Extraction Process
2.3. Dyeing Process
2.4. Mordanting Process for Shade Development
2.5. Shade Improvement Process
2.6. Evaluation of Colorant Efficacy
2.7. Analysis of the Rose Extract
3. Results and Discussion
3.1. Spectroscopic Analysis of Dye Solution (FTIR)
3.2. Antibacterial Activity
3.3. Optimization of Dyeing Parameters
3.4. Mordanting
3.5. Fastness Properties
4. Conclusions
Supplementary Materials
Author Contributions
Funding
Institutional Review Board Statement
Informed Consent Statement
Data Availability Statement
Conflicts of Interest
References
- Adeel, S.; Kiran, S.; Abbas, M.; Batool, F.; Hussaan, M.; Amin, N. Sustainable isolation of licorice (Glycyrrhiza glabra L.)-based yellow natural colorant for dyeing of bio-mordanted cotton. Environ. Sci. Pollut. Res. 2022, 29, 31270–31277. [Google Scholar] [CrossRef]
- Meng, X.; Scheidemantle, B.; Li, M.; Wang, Y.-y.; Zhao, X.; Toro-González, M.; Singh, P.; Pu, Y.; Wyman, C.E.; Ozcan, S. Synthesis, characterization, and utilization of a lignin-based adsorbent for effective removal of azo dye from aqueous solution. ACS Omega 2020, 5, 2865–2877. [Google Scholar] [CrossRef]
- Safapour, S.; Sadeghi-Kiakhani, M.; Eshaghloo-Galugahi, S. Extraction, dyeing, and antibacterial properties of crataegus elbursensis fruit natural dye on wool yarn. Fibers Polym. 2018, 19, 1428–1434. [Google Scholar] [CrossRef]
- Xu, X.; Gong, J.; Li, Z.; Li, Q.; Zhang, J.; Wang, L.; Huang, J. mordant free dyeing and functionalization of wool fabrics with biocolorants derived from apocynum venetum L. Bast. ACS Sustain. Chem. Eng. 2020, 8, 12686–12695. [Google Scholar] [CrossRef]
- Malinauskiene, L.; Zimerson, E.; Bruze, M.; Ryberg, K.; Isaksson, M. Are allergenic disperse dyes used for dyeing textiles? Cont. Derm. 2012, 67, 141–148. [Google Scholar] [CrossRef]
- Tiwari, A.; Joshi, M.; Salvi, N.; Gupta, D.; Gandhi, S.; Rajpoot, K.; Tekade, R.K. Toxicity of pharmaceutical azo dyes. In Pharmacokinetics and Toxicokinetic Considerations; Elsevier: Amsterdam, The Netherlands, 2022; pp. 569–603. [Google Scholar]
- Abou Oualid, H.; Abdellaoui, Y.; Laabd, M.; El Ouardi, M.; Brahmi, Y.; Iazza, M.; Abou Oualid, J. Eco-efficient green seaweed codium decorticatum biosorbent for textile dyes: Characterization, mechanism, recyclability, and RSM optimization. ACS Omega 2020, 5, 22192–22207. [Google Scholar] [CrossRef] [PubMed]
- Talebian, A.; Habibi, S.; Neshat, P. Green dyeing of weld on Corona discharge treated wool fabric. J. Text. Inst. 2021, 112, 144–151. [Google Scholar] [CrossRef]
- Adeel, S.; Fazal-ur-Rehman; Khosa, M.K.; Rajab, S.; Zia, K.M.; Zuber, M.; Batool, F. Eco-friendly isolation of colorant from arjun bark for dyeing of bio-mordanted cotton fabric: Short title: Dyeing of bio-mordanted cotton with arjun bark colorant. J. Nat. Fibers 2022, 19, 4684–4695. [Google Scholar] [CrossRef]
- Wang, W.-Y.; Chiou, J.-C.; Yip, J.; Yung, K.-F.; Kan, C.-W. Development of durable antibacterial textile fabrics for potential application in healthcare environment. Coatings 2020, 10, 520. [Google Scholar] [CrossRef]
- Xia, L.; Wang, A.; Wang, Y.; Zhang, C.; Wang, Y.; Zhou, S.; Fu, Z.; Zhao, H.; Ding, C.; Xu, W. Eco-friendly dyeing of raw cotton fibres in an ethanol–water mixture without scouring and bleaching pretreatments. Green Chem. 2021, 23, 796–807. [Google Scholar] [CrossRef]
- Adeel, S.; Salman, M.; Usama, M.; Fazal-ur-Rehman; Ahmad, T.; Amin, N. Sustainable Isolation and Application of Rose Petals Based Anthocyanin Natural Dye for Coloration of Bio-Mordanted Wool Fabric: Short title: Dyeing of Bio Mordanted Wool with Rose Petal Extract. J. Nat. Fibers 2022, 19, 6089–6103. [Google Scholar] [CrossRef]
- Khattab, T.A.; Abdelrahman, M.S.; Rehan, M. Textile dyeing industry: Environmental impacts and remediation. Environ. Sci. Pollut. Res. 2020, 27, 3803–3818. [Google Scholar] [CrossRef] [PubMed]
- Xia, L.; Wang, A.; Zhang, C.; Liu, Y.; Guo, H.; Ding, C.; Wang, Y.; Xu, W. Environmentally friendly dyeing of cotton in an ethanol–water mixture with excellent exhaustion. Green Chem. 2018, 20, 4473–4483. [Google Scholar] [CrossRef]
- Hosseinnezhad, M.; Gharanjig, K.; Jafari, R.; Imani, H.; Razani, N. Cleaner colorant extraction and environmentally wool dyeing using oak as eco-friendly mordant. Environ. Sci. Pollut. Res 2021, 28, 7249–7260. [Google Scholar] [CrossRef]
- Yadav, R.; Anubhav, M.P.; Sheikh, J. Antibacterial, UV protective and antioxidant linen obtained by natural dyeing with henna. Cellulose Chem. Technol. 2019, 53, 357–362. [Google Scholar] [CrossRef]
- Maleki, H.; Barani, H. Extraction and antibacterial activity of Pulicaria Gnaphalodes as a natural colorant: Characterization and application on wool fibers. Prog. Color. Color. Coat 2019, 12, 145–154. [Google Scholar]
- Wang, S.; Li, J.; Cao, Y.; Gu, J.; Wang, Y.; Chen, S. Non-leaching, rapid bactericidal and biocompatible polyester fabrics finished with benzophenone terminated n-halamine. Adv. Fiber Mater. 2022, 4, 119–128. [Google Scholar] [CrossRef]
- Rade, P.P.; Giram, P.S.; Shitole, A.A.; Sharma, N.; Garnaik, B. physicochemical and in vitro antibacterial evaluation of metronidazole loaded eudragit s-100 nanofibrous mats for the intestinal drug delivery. Adv. Fiber Mater. 2022, 4, 76–88. [Google Scholar] [CrossRef]
- Thakker, A.M.; Sun, D. Sustainable plant-based bioactive materials for functional printed textiles. J. Text. Inst. 2021, 112, 1324–1358. [Google Scholar] [CrossRef]
- Chakraborty, L.; Pandit, P.; Maulik, S.R. Acacia auriculiformis-A natural dye used for simultaneous coloration and functional finishing on textiles. J. Clean. Prod. 2020, 245, 118921. [Google Scholar] [CrossRef]
- Senapitakkul, V.; Vanitjinda, G.; Torgbo, S.; Pinmanee, P.; Nimchua, T.; Rungthaworn, P.; Sukatta, U.; Sukyai, P. Pretreatment of cellulose from sugarcane bagasse with xylanase for improving dyeability with natural dyes. Acs Omega 2020, 5, 28168–28177. [Google Scholar] [CrossRef] [PubMed]
- Haji, A. Natural dyeing of wool with henna and yarrow enhanced by plasma treatment and optimized with response surface methodology. J. Text. Inst. 2020, 111, 467–475. [Google Scholar] [CrossRef]
- Haji, A. Application of D-optimal design in the analysis and modelling of dyeing of plasma-treated wool with three natural dyes. Color. Technol. 2020, 136, 137–146. [Google Scholar] [CrossRef]
- Ozturk, E.; Cinperi, N.C.; Kitis, M. Green textile production: A chemical minimization and substitution study in a woolen fabric production. Environ. Sci. Pollut. Res. 2020, 27, 45358–45373. [Google Scholar] [CrossRef] [PubMed]
- Cui, L.; Yuan, J.; Wang, P.; Wang, X.; Fan, X.; Wang, Q. An ecofriendly phosphorylation of wool using Maillard reaction for improving cationic dye absorption. J. Clean. Prod. 2018, 178, 611–617. [Google Scholar] [CrossRef]
- Shim, S.H.; Kim, J.M.; Choi, C.Y.; Kim, C.Y.; Park, K.H. Ginkgo biloba extract and bilberry anthocyanins improve visual function in patients with normal tension glaucoma. J. Med. Food 2012, 15, 818–823. [Google Scholar] [CrossRef]
- Baena-Baldiris, D.; Montes-Robledo, A.; Baldiris-Avila, R. Franconibacter sp., 1MS: A new strain in decolorization and degradation of azo dyes ponceau s red and methyl orange. ACS Omega 2020, 5, 28146–28157. [Google Scholar] [CrossRef]
- Kwon, E.-K.; Lee, D.-Y.; Lee, H.; Kim, D.-O.; Baek, N.-I.; Kim, Y.-E.; Kim, H.-Y. Flavonoids from the buds of Rosa damascena inhibit the activity of 3-hydroxy-3-methylglutaryl-coenzyme a reductase and angiotensin I-converting enzyme. J. Agric. Food Chem. 2010, 58, 882–886. [Google Scholar] [CrossRef]
- Houston, D.M.; Bugert, J.; Denyer, S.P.; Heard, C.M. Anti-inflammatory activity of Punica granatum L.(Pomegranate) rind extracts applied topically to ex vivo skin. Eur. J. Pharm. Biopharm. 2017, 112, 30–37. [Google Scholar] [CrossRef] [PubMed]
- Bai, C.Z.; Feng, M.L.; Hao, X.L.; Zhao, Z.J.; Li, Y.Y.; Wang, Z.H. Anti-tumoral effects of a trypsin inhibitor derived from buckwheat in vitro and in vivo. Mol. Med. Rep. 2015, 12, 1777–1782. [Google Scholar] [CrossRef]
- Adeel, S.; Kiran, S.; Shahid, M.; Habib, S.R.; Habib, N.; Hussaan, M. Ecofriendly application of coconut coir (Cocos nucifera) extract for silk dyeing. Environ. Sci. Pollut. Res. 2022, 29, 564–572. [Google Scholar] [CrossRef] [PubMed]
- Dulman, V.; Lisa, G.; Bobu, E.; Asandei, D. Adsorption of certain textile dyes onto chitosan. Spectroscopic and thermal analysis. Cellul. Chem. Technol. 2020, 54, 149–158. [Google Scholar] [CrossRef]
- Wizi, J.; Wang, L.; Hou, X.; Tao, Y.; Ma, B.; Yang, Y. Ultrasound-microwave assisted extraction of natural colorants from sorghum husk with different solvents. Ind. Crops Prod. 2018, 120, 203–213. [Google Scholar] [CrossRef]
- Cisowska, A.; Wojnicz, D.; Hendrich, A.B. anthocyanins as antimicrobial agents of natural plant origin. Nat. Prod. Commun. 2011, 6, 1934578X1100600136. [Google Scholar] [CrossRef]
- Kamali Moghaddam, M.; Ghanbari Adivi, M.; Tehrani Dehkordi, M. Effect of acids and different mordanting procedures on color characteristics of dyed wool fibers using eggplant peel (Solanum melongena L.). Prog. Color. Color. Coat 2019, 12, 219–230. [Google Scholar]
- Yusuf, M.; Mohammad, F.; Shabbir, M.; Khan, M.A. Eco-dyeing of wool with Rubia cordifolia root extract: Assessment of the effect of Acacia catechu as biomordant on color and fastness properties. Text. Cloth. Sustain. 2017, 2, 10. [Google Scholar] [CrossRef]
- Punyachareonnon, P.; Deerattrakul, V.; Luepong, K. The influence of pH, temperature and time on dyeing of silk fabric by black bean anthocyanin-rich extract as colorant. Prog. Color. Color. Coat 2021, 14, 179–186. [Google Scholar]
- Zhou, Q.; Wang, W.; Zhang, Y.; Hurren, C.J.; Li, Q. Analyzing the thermal and hygral behavior of wool and its impact on fabric dimensional stability for wool processing and garment manufacturing. Text. Res. J. 2020, 90, 2175–2183. [Google Scholar] [CrossRef]
- Ashrafi, N.; Gharanjig, K.; Hosseinnezhad, M.; Khajeh Mehrizi, M.; Imani, H.; Razani, N. Dyeing properties and color fabrics using natural dye and mordant. Prog. Color. Color. Coat 2018, 11, 79–83. [Google Scholar]
- Habib, N.; Akram, W.; Adeel, S.; Amin, N.; Hosseinnezhad, M.; Haq, E.u. Environmental-friendly extraction of Peepal (Ficus Religiosa) bark-based reddish brown tannin natural dye for silk coloration. Environ. Sci. Pollut. Res. 2022, 29, 35048–35060. [Google Scholar] [CrossRef]
- Haddar, W.; Ben Ticha, M.; Meksi, N.; Guesmi, A. Application of anthocyanins as natural dye extracted from Brassica oleracea L. var. capitata f. rubra: Dyeing studies of wool and silk fibres. Nat. Prod. Res. 2018, 32, 141–148. [Google Scholar] [CrossRef]
- Araújo, P.; Basílio, N.; Azevedo, J.; Fernandes, A.; Mateus, N.; Pina, F.; de Freitas, V.; Oliveira, J. Colour modulation of blue anthocyanin-derivatives. Lignosulfonates as a tool to improve the water solubility of natural blue dyes. Dyes Pigm. 2018, 153, 150–159. [Google Scholar] [CrossRef]
- Haji, A.; Payvandy, P. Application of ANN and ANFIS in prediction of color strength of plasma-treated wool yarns dyed with a natural colorant. Pigment. Resin Technol. 2020, 49, 171–180. [Google Scholar] [CrossRef]
- Hosseinnezhad, M.; Gharanjig, K.; Razani, N.; Imani, H. Green dyeing of wool fibers with madder: Study of combination of two biomordant on K/S and fastness. Fibers Polym. 2020, 21, 2036–2041. [Google Scholar] [CrossRef]
- dos Santos Silva, P.M.; Fiaschitello, T.R.; de Queiroz, R.S.; Freeman, H.S.; da Costa, S.A.; Leo, P.; Montemor, A.F.; da Costa, S.M. Natural dye from Croton urucurana Baill. bark: Extraction, physicochemical characterization, textile dyeing and color fastness properties. Dyes Pigm. 2020, 173, 107953. [Google Scholar] [CrossRef]
- Liyanapathiranage, A.; Peña, M.J.; Sharma, S.; Minko, S. Nanocellulose-based sustainable dyeing of cotton textiles with minimized water pollution. ACS Omega 2020, 5, 9196–9203. [Google Scholar] [CrossRef]

| Rose Extract Medium | Against Escherichia coli | Against Staphylococcus aureus | ||
|---|---|---|---|---|
| Extract | Dyed Fabric | Extract | Dyed Fabric | |
| Acidic | (a) 24.0 ± 1.00 mm | (e) 7.0 ± 0.78 mm | (a) 21.0 ± 1.00 mm | (e) 7.0 ± 0.34 mm |
| Aqueous | (b) 18.0 ± 1.00 mm | (f) 8.0 ± 1.00 mm | (b) 15.0 ± 1.00 mm | (f) 8.0 ± 1.00 mm |
| Alkaline | (c) 17.0 ± 1.00 mm | (g) 9.0 ± 1.00 mm | (c) 14.0 ± 1.00 mm | (g) 9.0 ± 1.00 mm |
| Basified Methanol | (d) 16.0 ± 0.57 mm | (h) 17.0 ± 1.00 mm | (d) 14.0 ± 1.00 mm | (h) 13.0 ± 1.00 mm |
| (a) | ||||||||||||
|---|---|---|---|---|---|---|---|---|---|---|---|---|
| Aqueous | ||||||||||||
| Pre | Post | |||||||||||
| Mordant | Conc. | LF | DRF | WRF | DCF | WF | Conc. | LF | DRF | WRF | DCF | WF |
| C.C | C.C | |||||||||||
| Al3+ | 5% | 4 | 4/5 | 3/4 | 4 | 4/5 | 5% | 4 | 5 | 4/5 | 4/5 | 4/5 |
| Fe2− | 7% | 4 | 4 | 3 | 4/5 | 4/5 | 5% | 4 | 4/5 | 3 | 4 | 4/5 |
| TA | 7% | 4 | 5 | 3/4 | 4/5 | 4/5 | 1% | 4 | 5 | 3/4 | 4/5 | 4/5 |
| Tu | 3% | 4 | 5 | 3/4 | 4/5 | 4/5 | 1% | 4 | 4/5 | 3 | 4/5 | 4/5 |
| Pg | 5% | 4 | 5 | 4/5 | 4/5 | 4/5 | 5% | 4 | 5 | 3/4 | 4/5 | 4/5 |
| Acidic | ||||||||||||
| Pre | Post | |||||||||||
| Mordant | Conc. | LF | DRF | WRF | DCF | WF | Conc. | LF | DRF | WRF | DCF | WF |
| C.C | C.C | |||||||||||
| Al3+ | 5% | 4/5 | 4 | 3 | 4 | 4/5 | 5% | 4/5 | 4/5 | 3/4 | 4/5 | 4/5 |
| Fe2− | 7% | 4/5 | 4/5 | 3/4 | 4/5 | 4 | 5% | 4/5 | 4 | 3 | 4 | 4/5 |
| TA | 7% | 4/5 | 4/5 | 3 | 4/5 | 4/5 | 1% | 4/5 | 4 | 3/4 | 4/5 | 4/5 |
| Tu | 3% | 4/5 | 4/5 | 3 | 4/5 | 4/5 | 1% | 4/5 | 4/5 | 3 | 4/5 | 4/5 |
| Pg | 5% | 4/5 | 5 | 3/4 | 4/5 | 4 | 5% | 4/5 | 4/5 | 3/4 | 5 | 4/5 |
| (b) | ||||||||||||
| Alkaline | ||||||||||||
| Pre | Post | |||||||||||
| Mordant | Conc. | LF | DRF | WRF | DCF | WF | Conc. | LF | DRF | WRF | DCF | WF |
| C.C | C.C | |||||||||||
| Al3+ | 3% | 3 | 4/5 | 4 | 4 | 4/5 | 5% | 3 | 5 | 4/5 | 4/5 | 4/5 |
| Fe2− | 5% | 3 | 4 | 3/4 | 4/5 | 4/5 | 3% | 3 | 3/4 | 3/4 | 4/5 | 4 |
| TA | 7% | 3 | 4/5 | 3 | 4/5 | 4/5 | 1% | 3 | 5 | 3/4 | 4/5 | 4/5 |
| Tu | 9% | 3 | 4/5 | 4/5 | 4/5 | 4/5 | 5% | 3 | 5 | 3/4 | 4/5 | 4/5 |
| Pg | 1% | 3 | 5 | 3/4 | 4/5 | 4 | 3% | 3 | 5 | 3/4 | 4/5 | 4/5 |
| Basified Methanol | ||||||||||||
| Pre | Post | |||||||||||
| Mordant | Conc. | LF | DRF | WRF | DCF | WF | Conc. | LF | DRF | WRF | DCF | WF |
| C.C | C.C | |||||||||||
| Al3+ | 1% | 4/5 | 4/5 | 3/4 | 4/5 | 4 | 5% | 4/5 | 4/5 | 4/5 | 4 | 4/5 |
| Fe2− | 1% | 4/5 | 4 | 3/4 | 4/5 | 4/5 | 3% | 4/5 | 4/5 | 3/4 | 4/5 | 4/5 |
| TA | 3% | 4/5 | 5 | 3/4 | 4 | 4/5 | 5% | 4/5 | 5 | 3/4 | 4/5 | 4/5 |
| Tu | 7% | 4/5 | 5 | 4/5 | 4 | 4/5 | 3% | 4/5 | 5 | 4/5 | 4 | 4/5 |
| Pg | 5% | 4/5 | 5 | 4 | 4/5 | 4/5 | 9% | 4/5 | 5 | 3/4 | 4 | 4/5 |
Disclaimer/Publisher’s Note: The statements, opinions and data contained in all publications are solely those of the individual author(s) and contributor(s) and not of MDPI and/or the editor(s). MDPI and/or the editor(s) disclaim responsibility for any injury to people or property resulting from any ideas, methods, instructions or products referred to in the content. |
© 2023 by the authors. Licensee MDPI, Basel, Switzerland. This article is an open access article distributed under the terms and conditions of the Creative Commons Attribution (CC BY) license (https://creativecommons.org/licenses/by/4.0/).
Share and Cite
Salman, M.; Fazal-ur-Rehman; Adeel, S.; Habib, N.; Batool, F.; Usama, M.; Iqbal, F.; Fatima, A. Extraction of Anthocyanin from Rose Petals for Coloration of Biomordanted Wool Fabric. Coatings 2023, 13, 623. https://doi.org/10.3390/coatings13030623
Salman M, Fazal-ur-Rehman, Adeel S, Habib N, Batool F, Usama M, Iqbal F, Fatima A. Extraction of Anthocyanin from Rose Petals for Coloration of Biomordanted Wool Fabric. Coatings. 2023; 13(3):623. https://doi.org/10.3390/coatings13030623
Chicago/Turabian StyleSalman, Mahwish, Fazal-ur-Rehman, Shahid Adeel, Noman Habib, Fatima Batool, Muhammad Usama, Fareeha Iqbal, and Arooj Fatima. 2023. "Extraction of Anthocyanin from Rose Petals for Coloration of Biomordanted Wool Fabric" Coatings 13, no. 3: 623. https://doi.org/10.3390/coatings13030623
APA StyleSalman, M., Fazal-ur-Rehman, Adeel, S., Habib, N., Batool, F., Usama, M., Iqbal, F., & Fatima, A. (2023). Extraction of Anthocyanin from Rose Petals for Coloration of Biomordanted Wool Fabric. Coatings, 13(3), 623. https://doi.org/10.3390/coatings13030623

